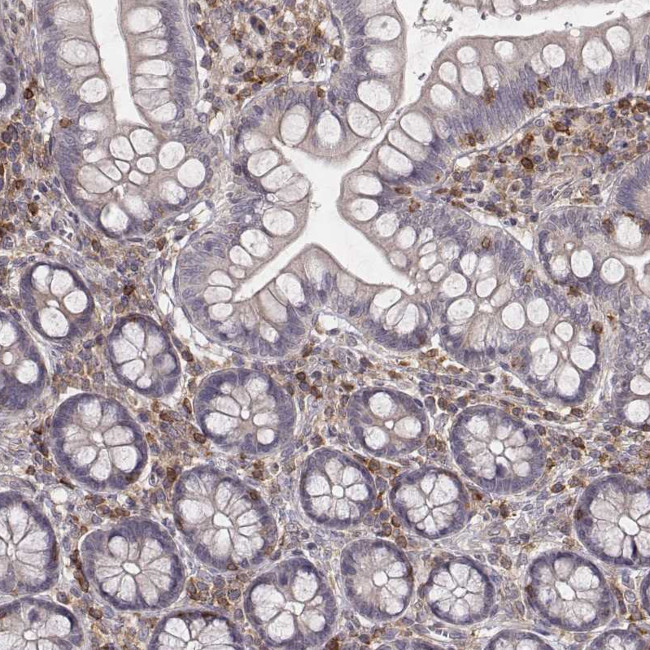
PILRA Antibody in Immunohistochemistry (Paraffin) (IHC (P))

Search
Invitrogen
PILRA Polyclonal Antibody
{{$productOrderCtrl.translations['antibody.pdp.commerceCard.promotion.promotions']}}
{{$productOrderCtrl.translations['antibody.pdp.commerceCard.promotion.viewpromo']}}
{{$productOrderCtrl.translations['antibody.pdp.commerceCard.promotion.promocode']}}: {{promo.promoCode}} {{promo.promoTitle}} {{promo.promoDescription}}. {{$productOrderCtrl.translations['antibody.pdp.commerceCard.promotion.learnmore']}}
产品信息
PA5-66000
种属反应
宿主/亚型
分类
类型
偶联物
形式
浓度
规格
纯化类型
保存液
内含物
保存条件
运输条件
RRID
产品详细信息
Immunogen sequence: ALSSSTSPRAP PSHRPLKSPQ NETLYSVLK
Highest antigen sequence identity to the following orthologs - mouse 50%, rat 57%.
靶标信息
SHP-1-mediated dephosphorylation of protein tyrosine residues is central to the regulation of several cell signaling pathways. Two types of inhibitory receptor superfamily members are immunoreceptor tyrosine-based inhibitory motif (ITIM)-bearing receptors and their non-ITIM-bearing, activating counterparts. Control of cell signaling via SHP-1 is thought to occur through a balance between PILRalpha-mediated inhibition and PILR beta-mediated activation. This particular gene encodes the ITIM-bearing member of the receptor pair, which functions in the inhibitory role.Cell signaling pathways rely on a dynamic interaction between activating and inhibiting processes. SHP-1-mediated dephosphorylation of protein tyrosine residues is central to the regulation of several cell signaling pathways. Two types of inhibitory receptor superfamily members are immunoreceptor tyrosine-based inhibitory motif (ITIM)-bearing receptors and their non-ITIM-bearing, activating counterparts. Control of cell signaling via SHP-1 is thought to occur through a balance between PILR alpha-mediated inhibition and PILRbeta-mediated activation. These paired immunoglobulin-like receptor genes are located in a tandem head-to-tail orientation on chromosome 7. This particular gene encodes the ITIM-bearing member of the receptor pair, which functions in the inhibitory role.
仅用于科研。不用于诊断过程。未经明确授权不得转售。
篇参考文献 (0)
生物信息学
蛋白别名: Cell surface receptor FDF03; Inhibitory receptor PILR-alpha; Paired immunoglobulin-like type 2 receptor alpha; unnamed protein product
基因别名: FDF03; PILRA
UniProt ID: (Human) Q9UKJ1
Entrez Gene ID: (Human) 29992